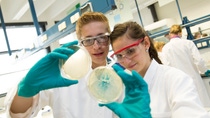
0387, Teens Lab, Xplore, Schüler, AP Nadine Vocino, H200 0387, Teens Lab, Xplore, Schüler, AP Nadine Vocino, H200

Наш фокус
Про компанію
Ми створюємо хімію для сталого майбутнього
Ми поєднуємо економічні успіхи з дбайливим ставленням до навколишнього середовища та соціальною відповідальністю.
Близько 112 000 співробітників BASF роблять внесок в успішний бізнес наших замовників у різноманітних секторах економіки й майже в усіх країнах світу.
Структура нашого бізнесу включає шість сегментів: хімічні речовини, матеріали, рішення для промисловості, поверхнево-активні речовини і технології, харчування і догляд, рішення для сільського господарства. У 2023 році BASF згенерував продажі у 68,9 млрд євро.
Погляд на BASF
Основні факти про концерн BASF за 2023 рік
68,9 млрд
обсяг продажів в Євро
234
виробничих майданчиків по всьому світу
16,9м
тонн викидів парникових газів